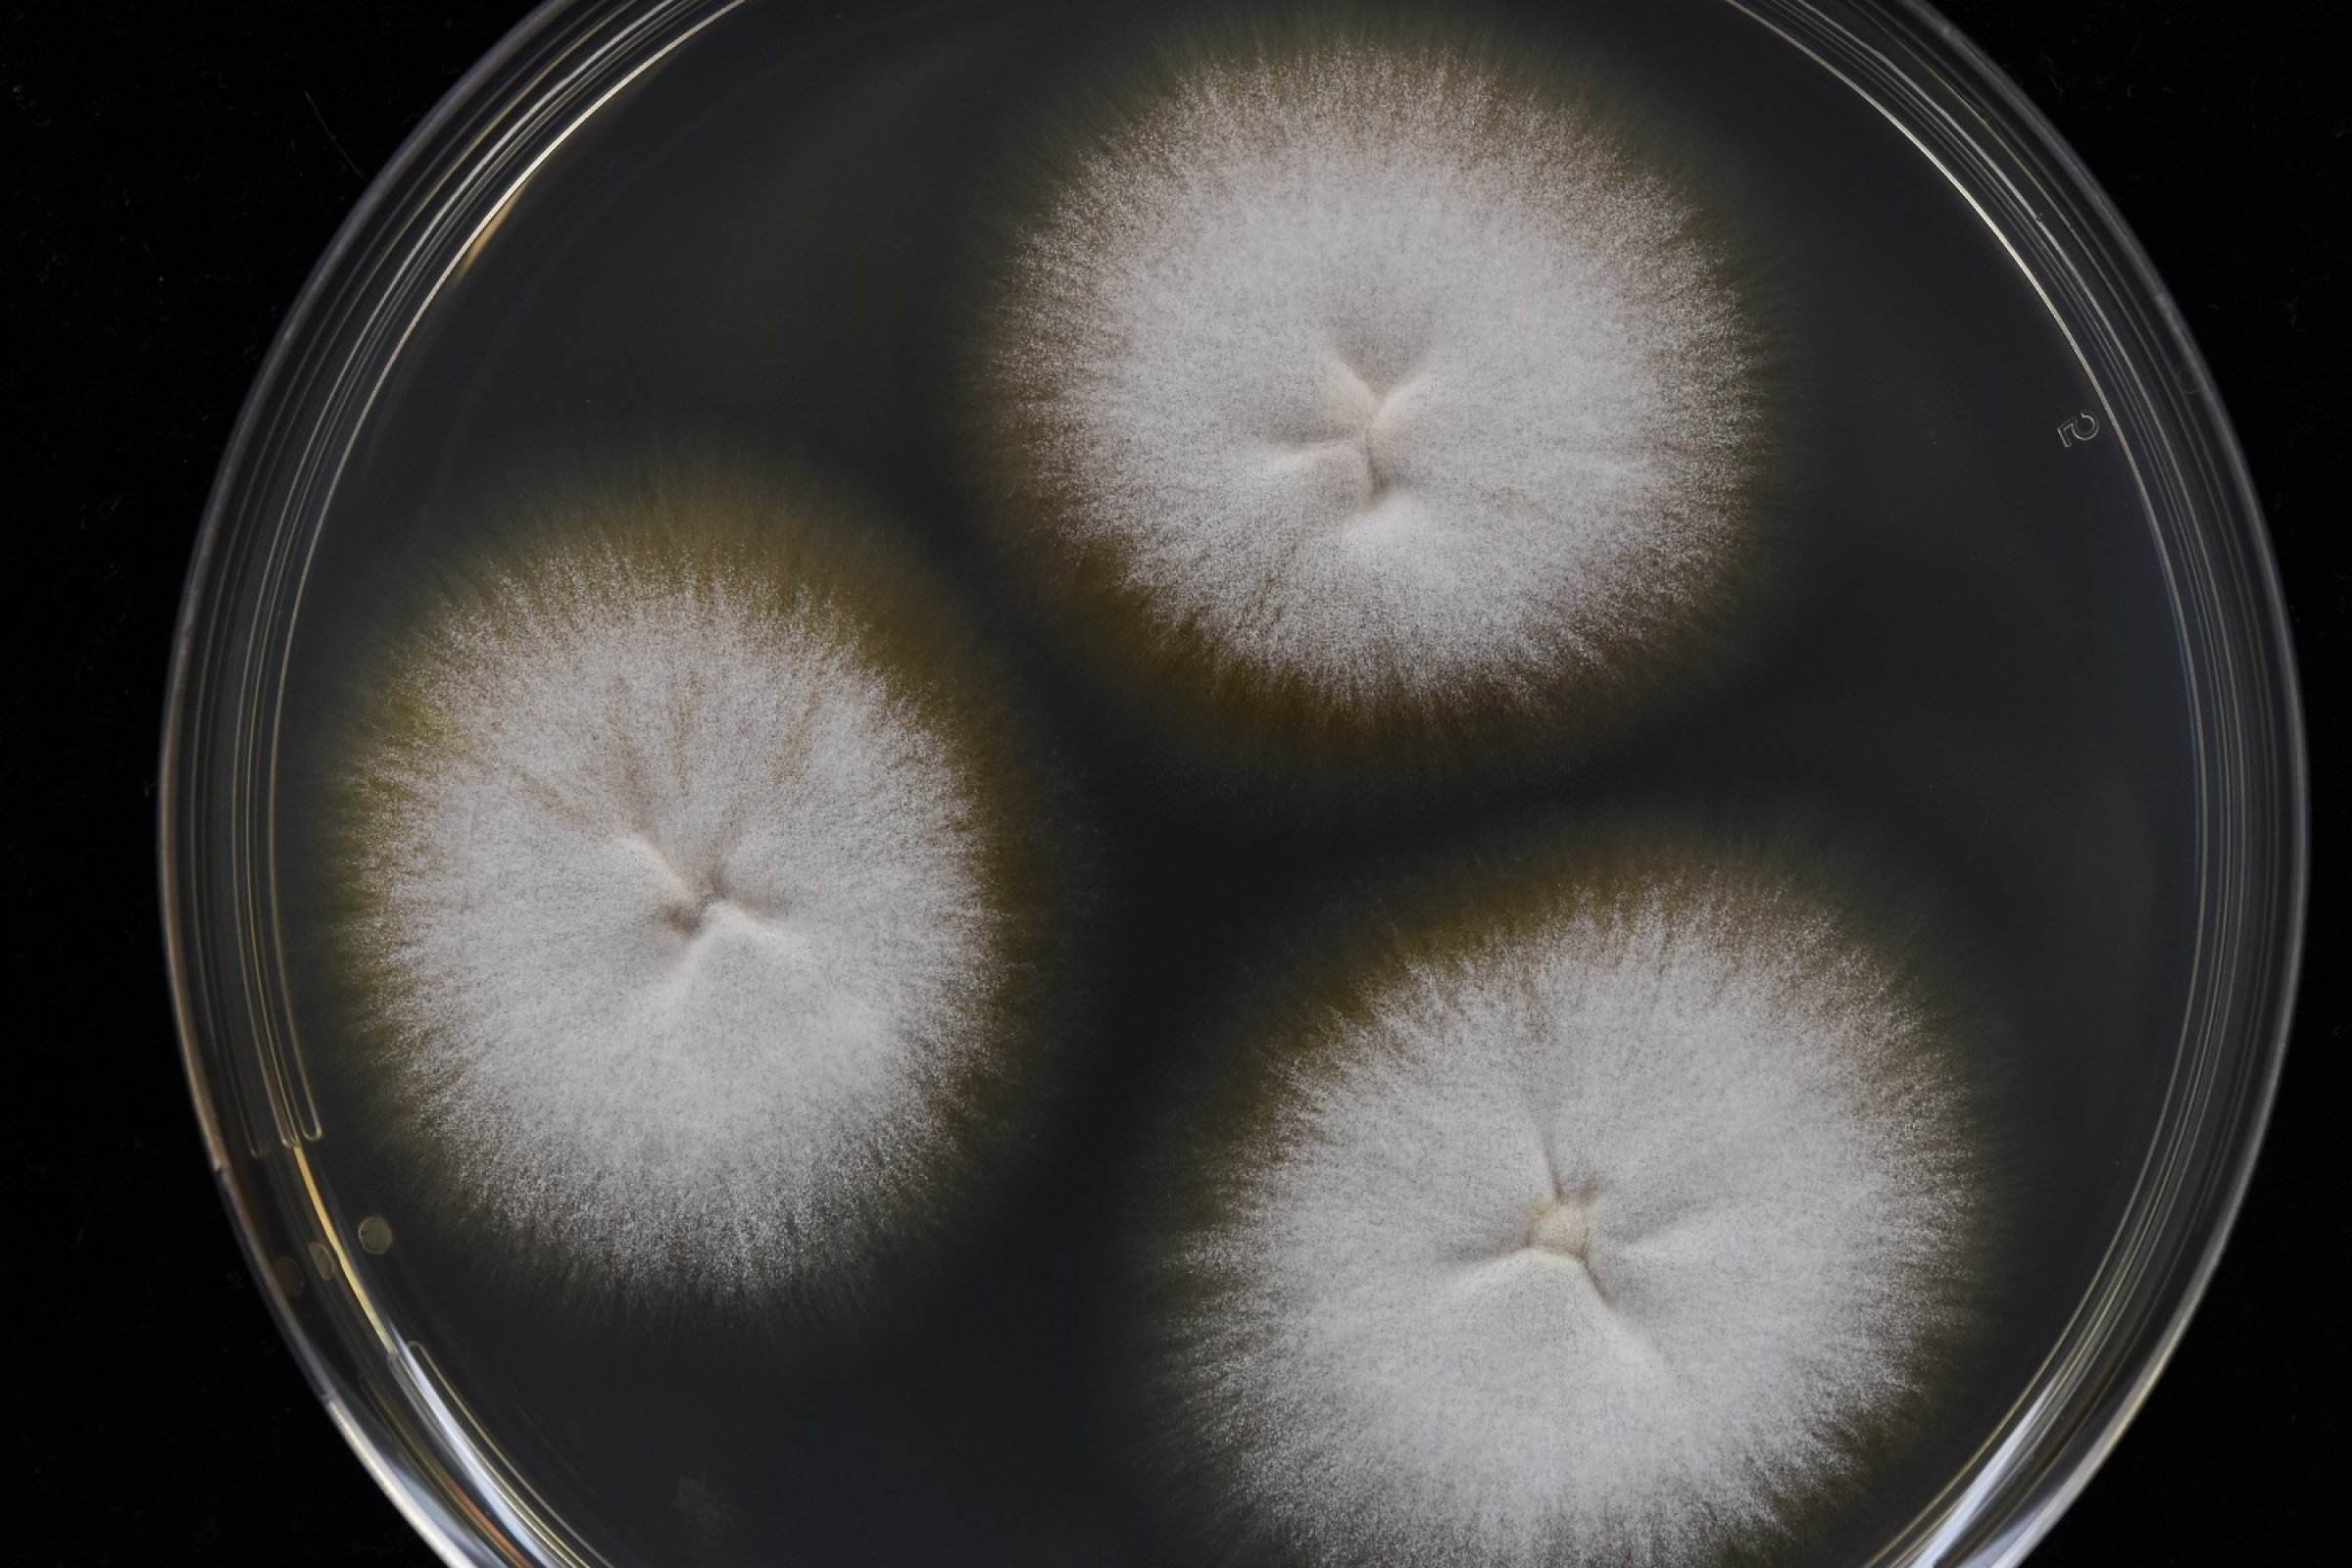
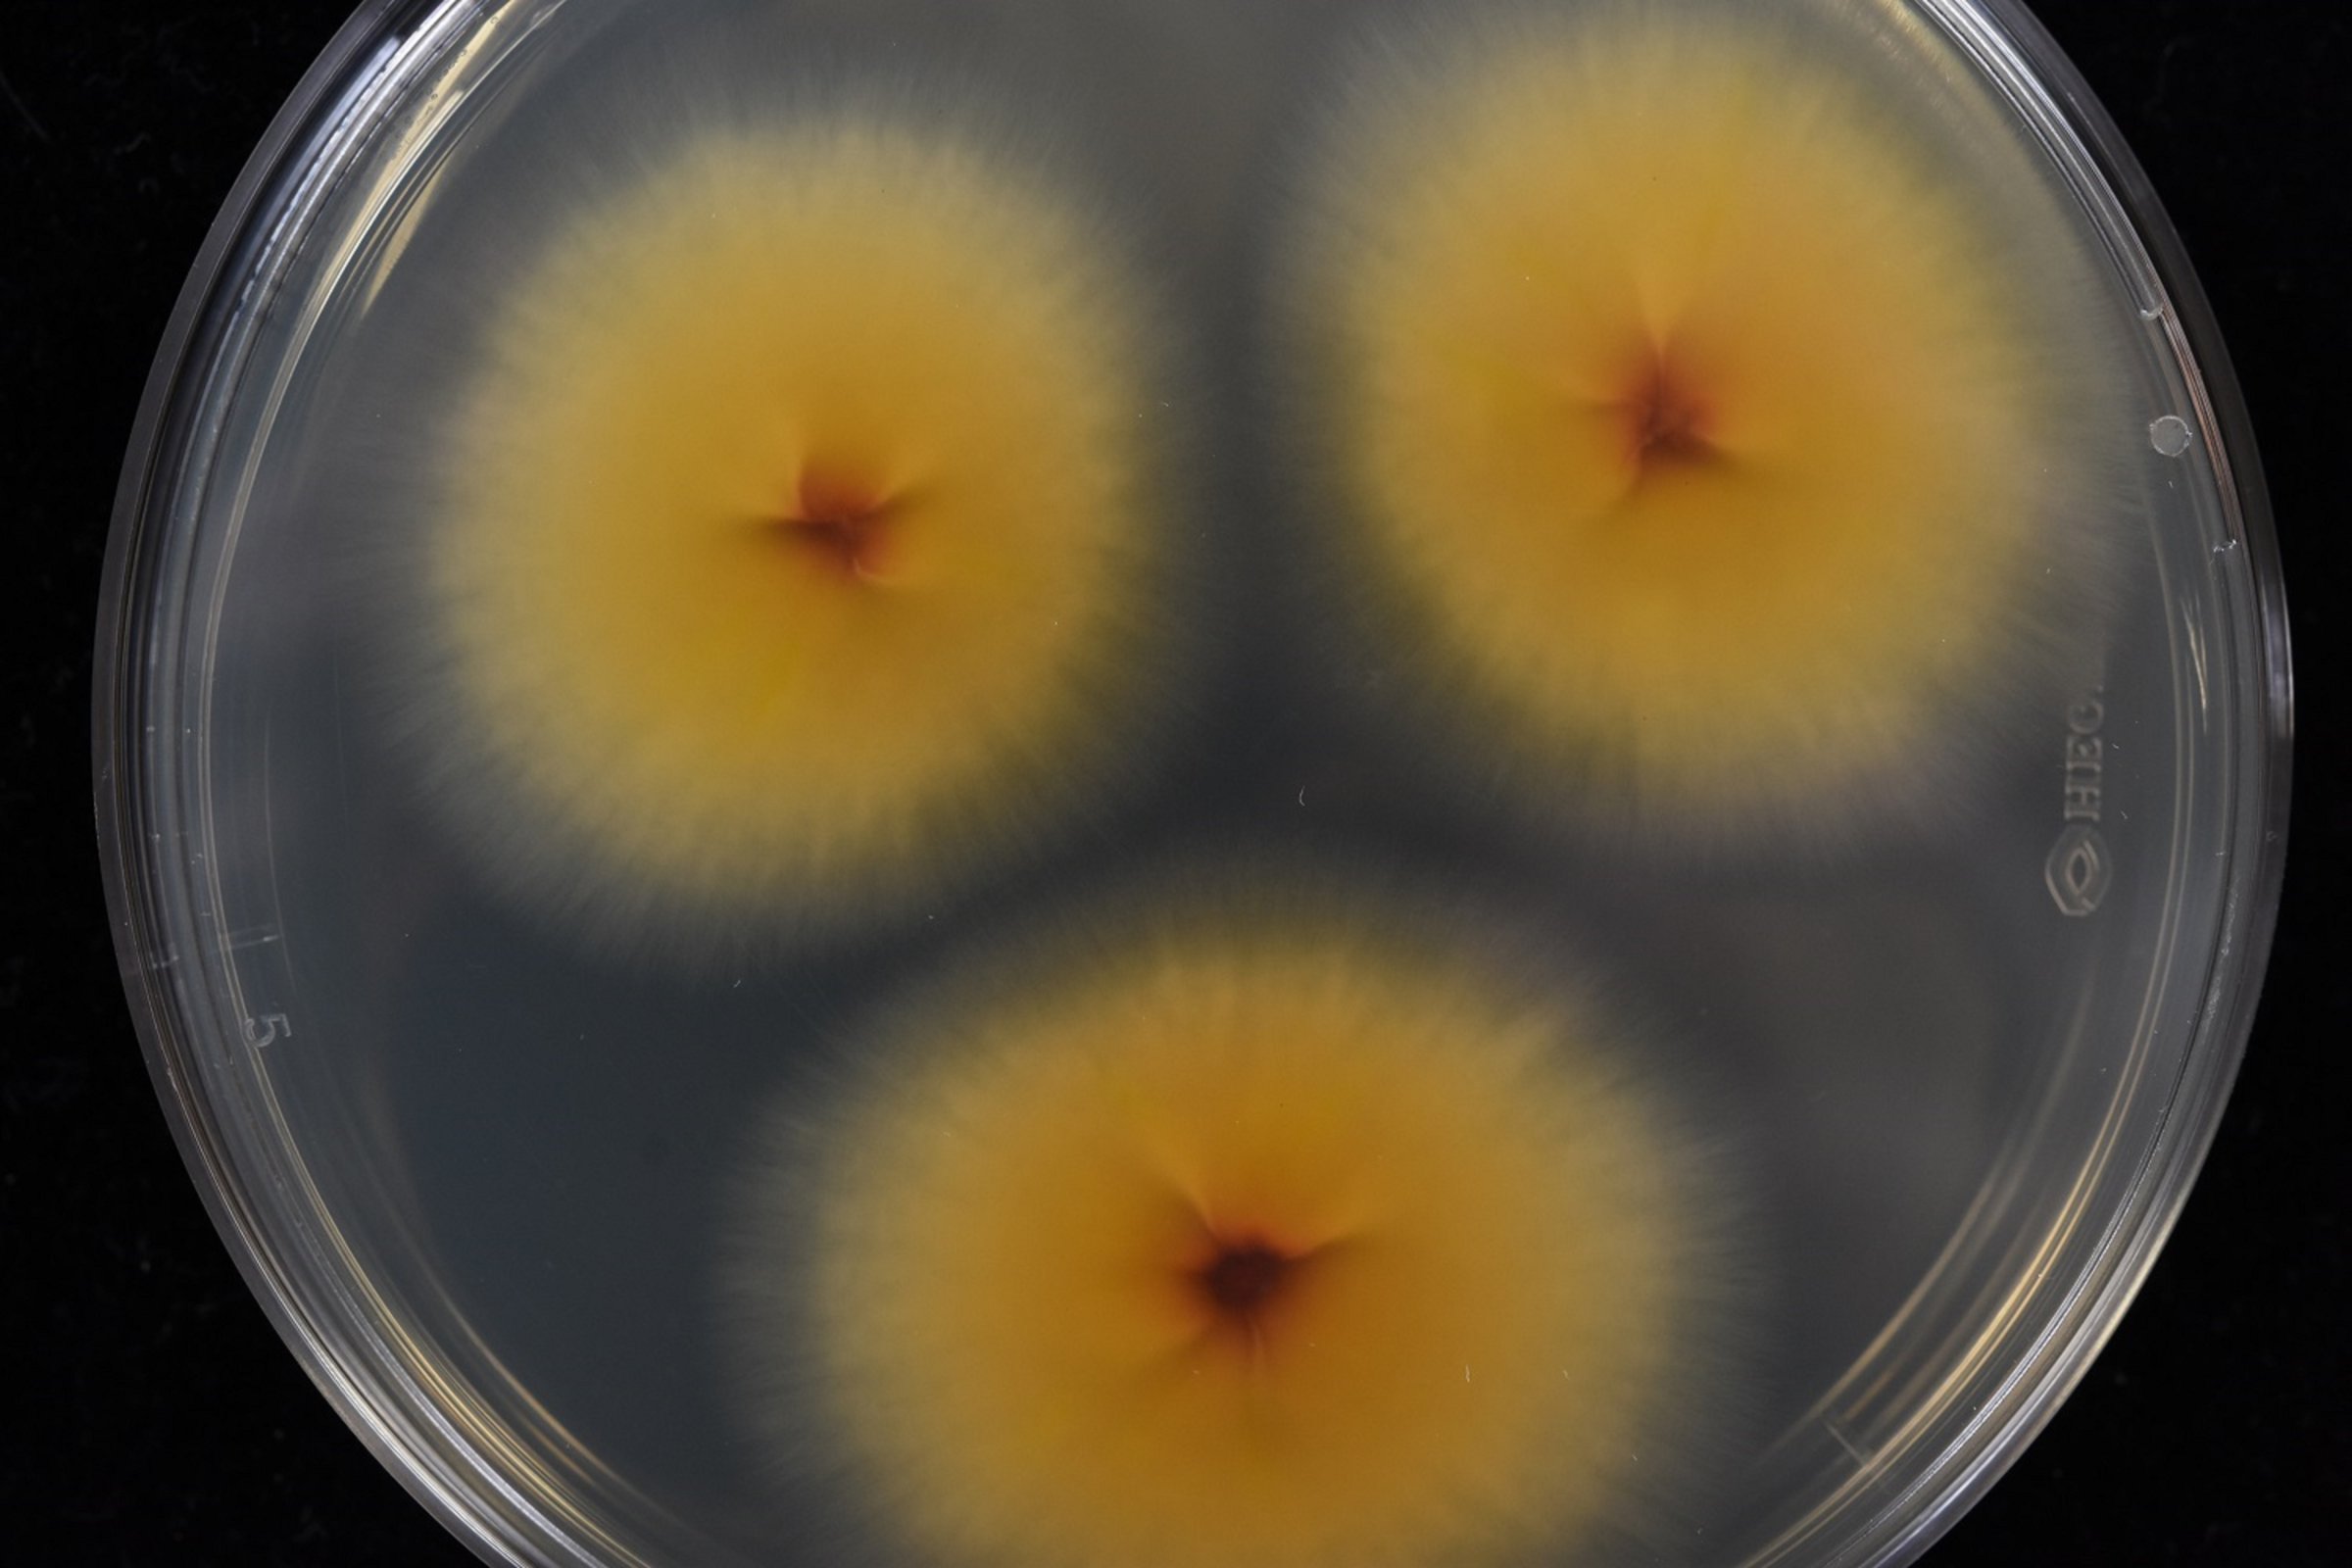

Ringorm på hest
Veterinærinstituttet har siden august påvist et økende antall tilfeller av ringorm på hest. Flesteparten av tilfellene er fra Vestland fylke.

Ringorm er en smittsom soppinfeksjon i det ytterste laget av huden, forårsaket av en soppgruppe som kalles dermatofytter. Hos hest er det arten Trichophyton equinum som den vanligste. Symptomene kan variere. Det starter ofte på hode, hals, rygg og begynner som små hevelser i huden med strittende hår. Etter hvert dannes hårløse flekker med ulik grad av flass og skorpedannelse.
Ved mistanke om ringorminfeksjon bør veterinær kontaktes og det bør tas en prøve av dyret som sendes inn til laboratoriet for dyrking.
Ringorm smitter lett fra dyr til dyr, ved transport og flytting av dyr for eksempel i forbindelse med stevner og konkurranser kan smitten spres mellom hestehold. Det er også en zoonose som kan smitte mellom dyr og mennesker. Ringorm hos hest er listeført som en C-sykdom og påvisning skal rapporteres til Mattilsynet.